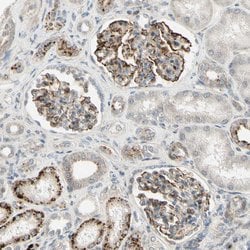
Invitrogen NDFIP1 Polyclonal Antibody 100 &mu;L; Unconjugated:Antibodies,

missing translation for 'onlineSavingsMsg'
Learn More
Learn More
Invitrogen™ NDFIP1 Polyclonal Antibody


Rabbit Polyclonal Antibody
Brand: Invitrogen™ PA552674
This item is not returnable.
View return policy
Description
Immunogen sequence: SRYQQLQNEE ESGEPEQAAG DAPPPYSSIS AESAAYFDYK DESGFPKP Highest antigen sequence identity to the following orthologs: Mouse - 92%, Rat - 90%.
The NEDD4 family-interacting protein 1 (NDFIP1) belongs to a small group of evolutionarily conserved proteins with three transmembrane domains and is an integral Golgi membrane protein. It is a potential target for ubiquitination by the Nedd4 family of proteins. NDFIP1 is strongly expressed in surviving neurons following acute cortical brain injury, and overexpression in cultured cortical neurons increased survival following growth factor starvation, suggesting that NDFIP1 may play a role in neuronal survival. NDFIP1 and the related protein NDFIP2 are thought to interact with and regulate multiple components of the EGF and PTEN/Akt signaling pathways. Recent studies suggest that NDFIP1 may also play a role in Th17 differentiation by limiting the production of proinflammatory cytokines.
Specifications
| NDFIP1 | |
| Polyclonal | |
| Unconjugated | |
| NDFIP1 | |
| 0610010M22Rik; Breast cancer-associated protein SGA-1M; N4wbp5; Ndfip1; Nedd4 family interacting protein 1; NEDD4 family-interacting protein 1; Nedd4 WW binding protein 5; NEDD4 WW domain-binding protein 5; Nedd4 WW-binding protein 5; PSEC0192; PSEC0223; Putative MAPK-activating protein PM13; putative NF-kappa-B-activating protein 164; Putative NFKB and MAPK-activating protein | |
| Rabbit | |
| Antigen Affinity Chromatography | |
| RUO | |
| 80762 | |
| Store at 4°C short term. For long term storage, store at -20°C, avoiding freeze/thaw cycles. | |
| Liquid |
| Immunohistochemistry (Paraffin), Western Blot | |
| 0.05 mg/mL | |
| PBS with 40% glycerol and 0.02% sodium azide; pH 7.2 | |
| Q9BT67 | |
| NDFIP1 | |
| Recombinant protein corresponding to Human NDFIP1. Recombinant protein control fragment (Product #RP-90219). | |
| 100 μL | |
| Primary | |
| Human | |
| Antibody | |
| IgG |
Product Content Correction
Your input is important to us. Please complete this form to provide feedback related to the content on this product.
Product Title
Spot an opportunity for improvement?Share a Content Correction